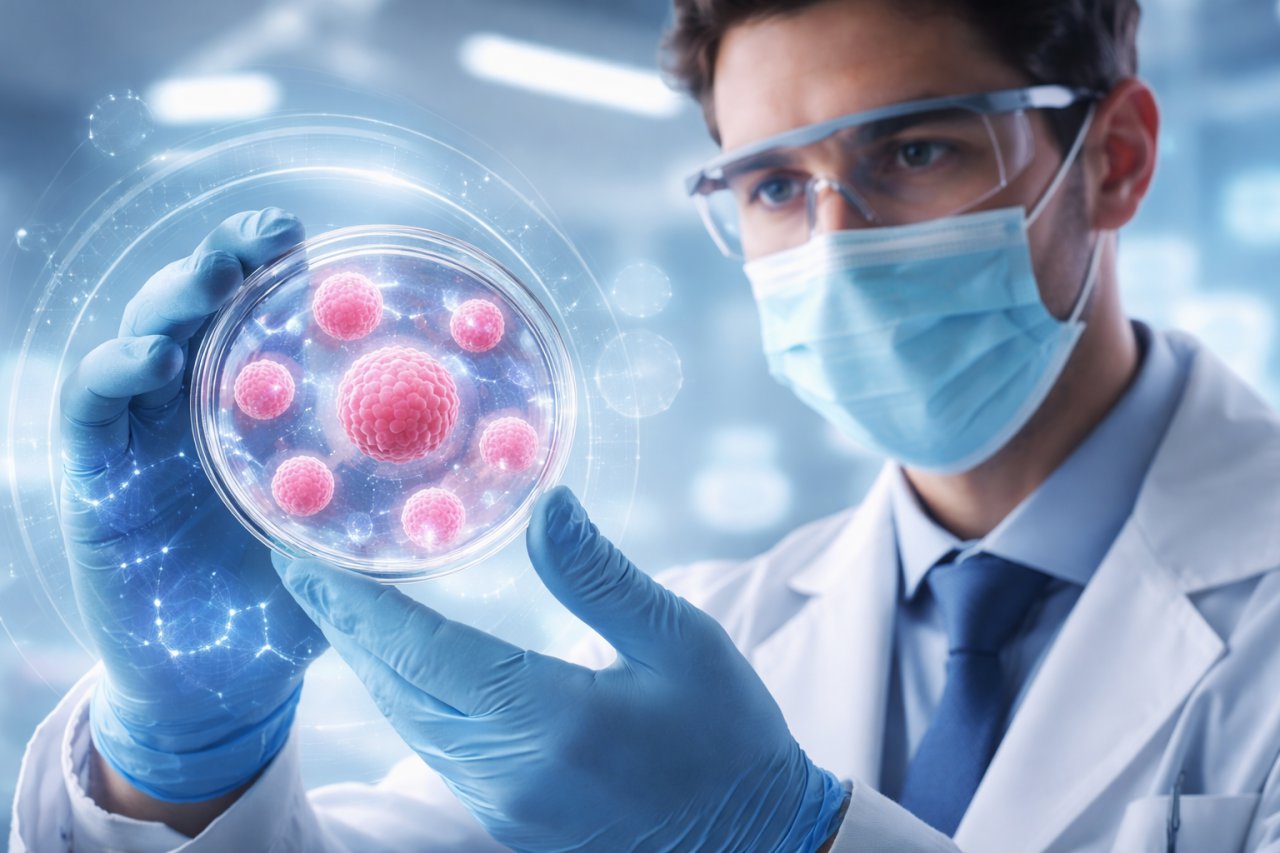

Сучасна медицина робить великий крок уперед завдяки інноваційним технологіям, що допомагають зміцнити здоров'я, підвищити енергію та продовжити активне життя. Однією з найбільш перспективних методик сьогодні є поєднання стовбурових клітин та екзосомної терапії, що відкриває нові горизонти в регенеративній медицині.
У клініці Vitality ці технології застосовуються для пацієнтів з усього світу, поєднуючи науку, сучасні методики та персоналізований підхід.
Vitality: Регенеративна медицина нового покоління
Клініка Vitality, що входить до медичної групи ADONIS, пропонує комплексні програми регенеративної медицини, засновані на використанні стовбурових клітин і екзосом. Цей підхід дозволяє активувати природний потенціал організму до відновлення, омолоджувати тканини, відновлювати нормальні функції систем та підтримувати довготривале здоров'я.
Програми клініки охоплюють такі напрямки:
- Антивікові та омолоджувальні програми
- Неврологія
- Офтальмологія
- Ортопедія та відновлення тканин
- Урологія та репродуктивне здоров'я
- Хірургія
- Ендокринологія
- Відновлення після COVID-19
- Повна діагностика та чекап
Кожна програма включає індивідуальний підхід, точне дозування клітин та ретельний нагляд на всіх етапах — від консультації до довготривалого супроводу.
Екзосоми: природний стимулятор відновлення
Особливу увагу в Vitality приділяють екзосомній терапії Exoprove.
Екзосоми — це мікроскопічні сигнальні молекули, які виділяються стовбуровими клітинами та містять білки, ліпіди та генетичні елементи.
Екзосоми сприятливо та комплексно впливають на весь організм, а саме:
- Покращують міжклітинну комунікацію
- Стимулюють відновлення пошкоджених тканин
- Зменшують запальні процеси
- Прискорюють регенерацію клітин
У поєднанні зі стовбуровими клітинами екзосоми підсилюють ефект терапії, скорочують терміни відновлення та покращують кінцевий результат лікування.
Досвід та технології світового рівня
Vitality має власну технологічну базу, яка включає:
- Ліцензований банк пуповинної крові та стовбурових клітин
- Дослідницькі лабораторії та кріобанк
- Банк Донорів генетичного матеріалу
Клініка оснащена сучасним обладнанням провідних виробників США та Європи, а лікарі є членами міжнародних медичних асоціацій. Кожна програма розробляється індивідуально, з урахуванням віку, стану здоров'я та цілей пацієнта.
Чому пацієнти обирають Vitality
Пацієнти з різних країн довіряють Vitality завдяки:
- Комплексному поєднанню стовбурових клітин та екзосом
- Власним лабораторіям та банкам біоматеріалів
- Персоналізованим програмам з точним підбором клітин
- Високим стандартам безпеки та контролю якості
- 16+ років досліджень у сфері клітинної терапії
- Цілодобовій підтримці та супроводу
Vitality — це не просто клініка. Це простір, де сучасна наука, турбота та інновації поєднуються для вашого здоров'я та довголіття.
Відкрийте для себе новий рівень регенеративної медицини з програмами стовбурових клітин та екзосом у Києві.
Vitality допоможе відновити енергію, покращити функціонування організму та підвищити якість вашого життя.